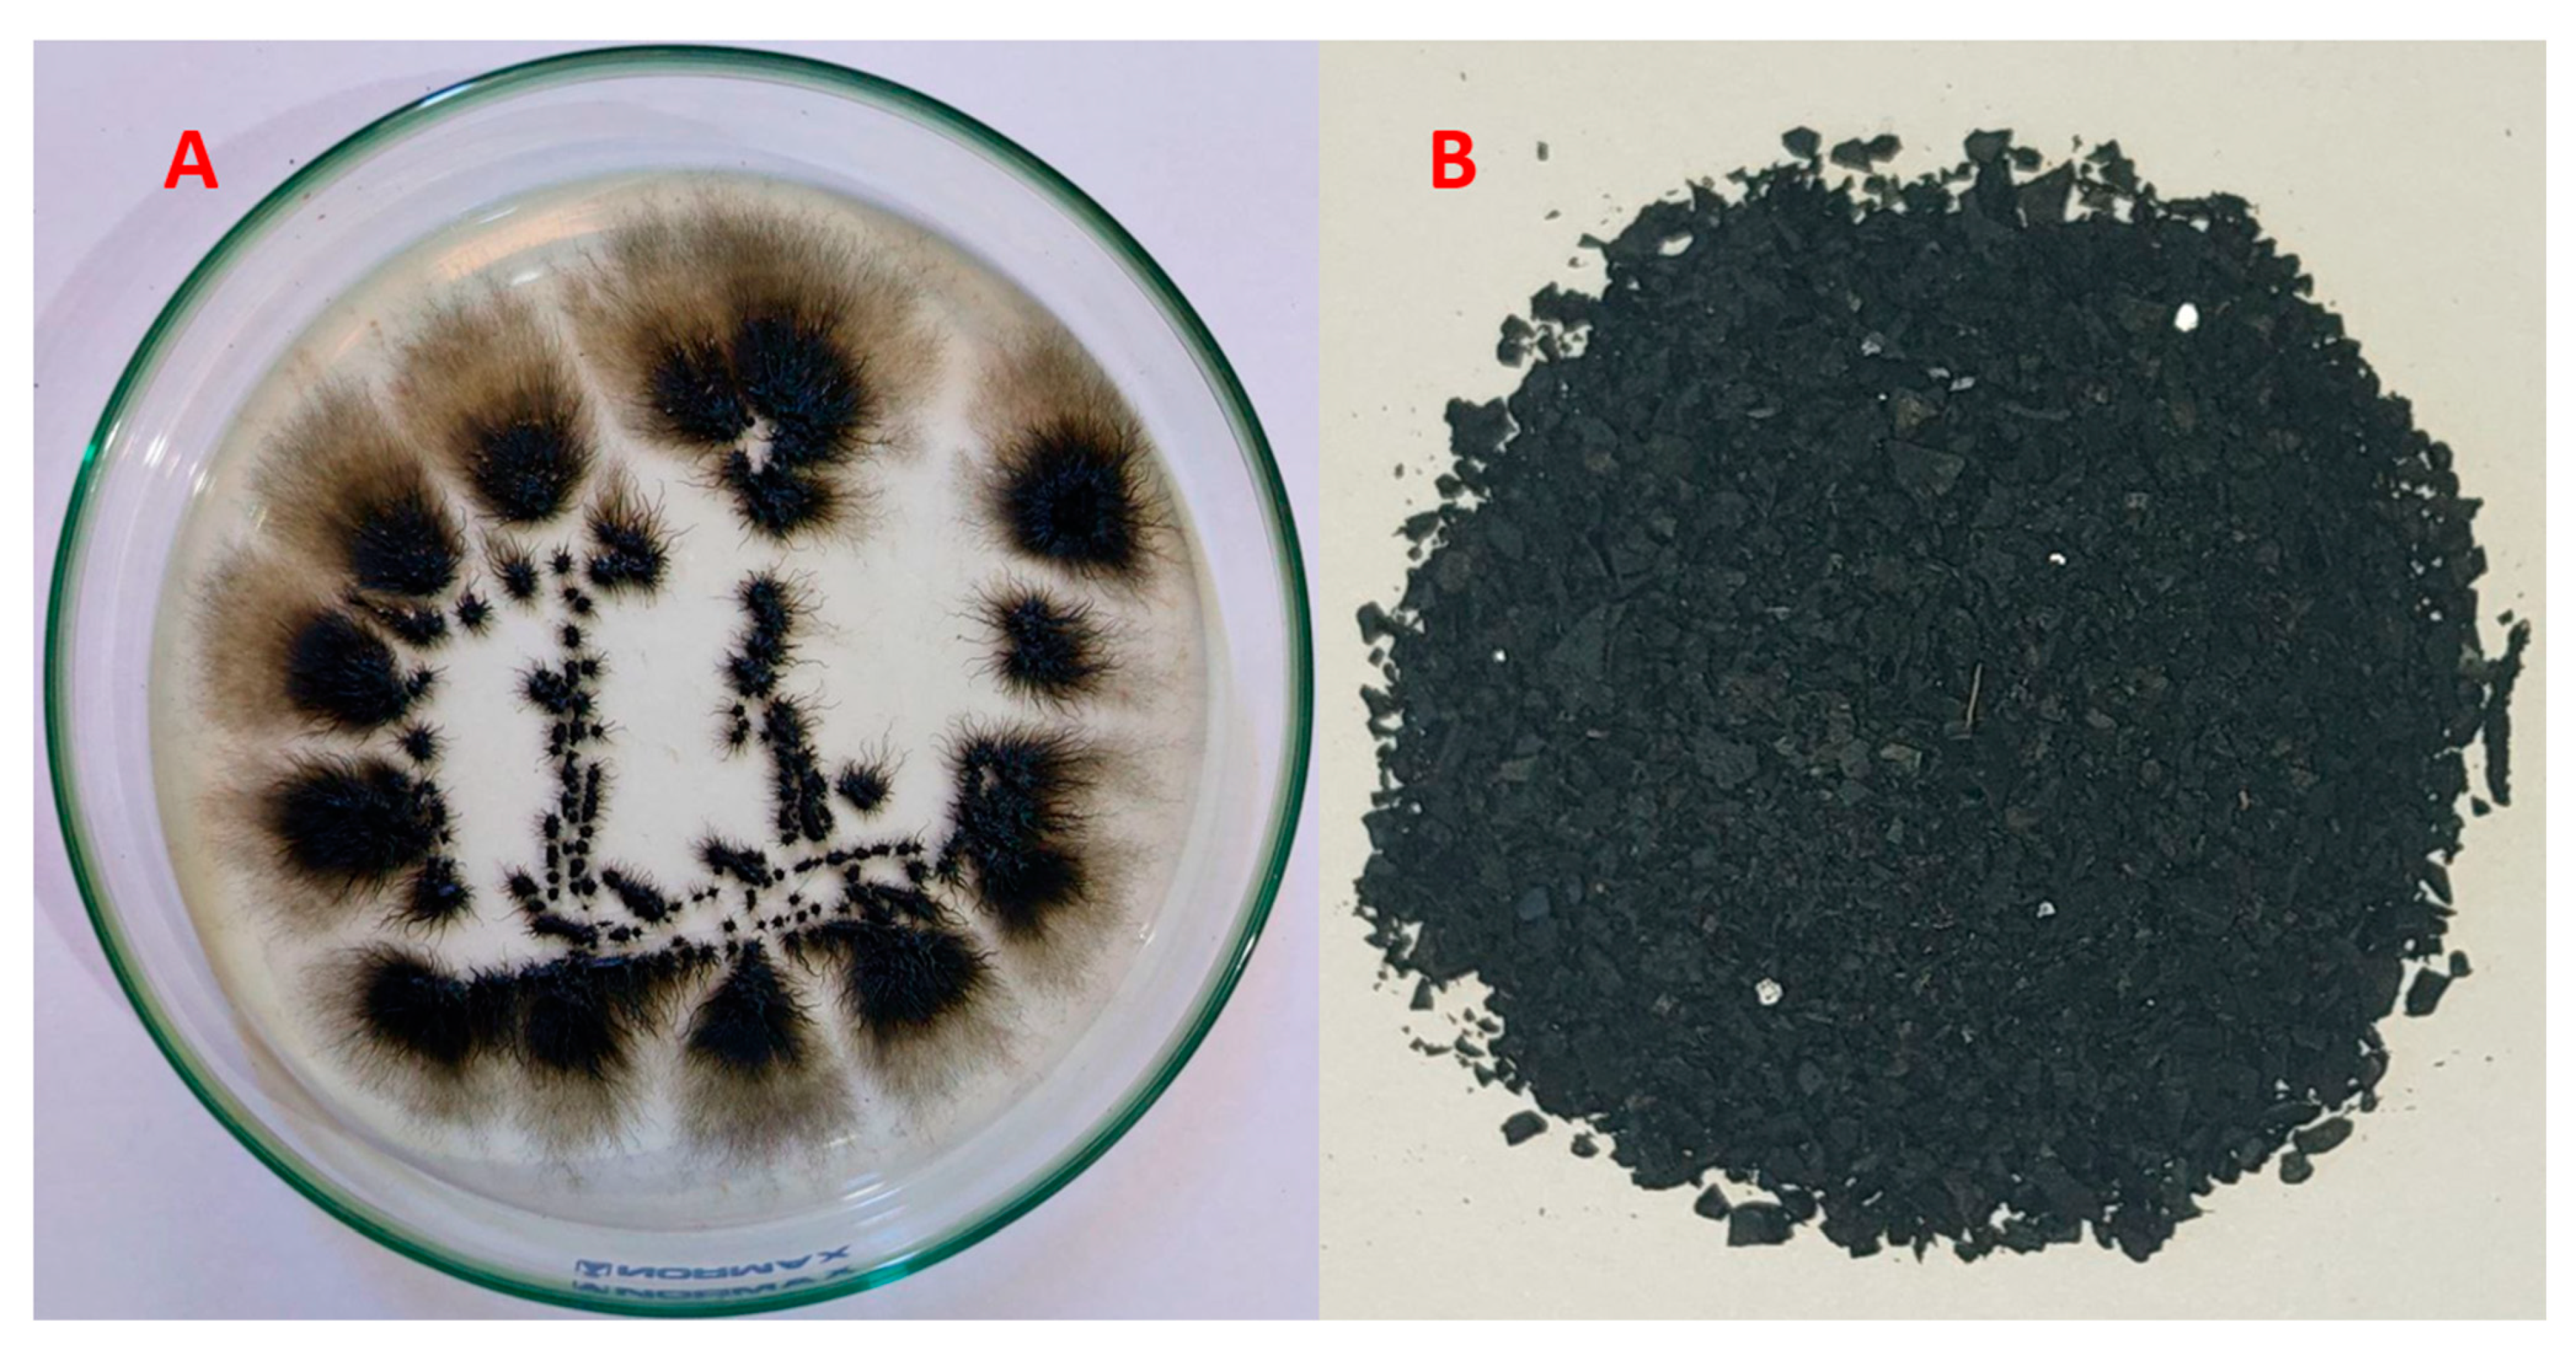
Polymers 15 03754 g001

A Comparative Study of Cr(VI) Sorption by Aureobasidium pullulans AKW Biomass and Its Extracellular Melanin: Complementary Modeling with Equilibrium Isotherms, Kinetic Studies, and Decision Tree Modeling
Abstract
:1. Introduction
2. Materials and Methods
2.1. Materials
2.2. Preparation of Hexavalent Chromium Solution
2.3. Preparation of Biosorbants
2.3.1. Fungus and Melanin
2.3.2. Separation and Purification of Melanin
2.4. Cr(VI) Ions Biosorption Process
2.4.1. Influence of Contact Time
2.4.2. Effect of Initial Cr(VI) Concentration
2.4.3. Effect of Thresholds of Fungal Biomass and Its Melanin
2.4.4. Solution pH vis. Cr(VI) Sorbtion
2.5. Biosorption Isotherm Determination
2.6. Biosorption Kinetic Studies
| Adsorption Kinetic Models | Equation | Parameter |
|---|---|---|
| Pseudo-first-order | qt and qe are the biosorbent Cr(VI) ions amount at time t and equilibrium (mg/g), respectively. k1 (min−1) is the first-order reaction rate constant | |
| Pseudo-second-order | qt and qe are the biosorbent Cr(VI) ions amount at time t and equilibrium (mg/g), respectively, and k2 is the second-order reaction rate equilibrium constant (g/mg/min). | |
| Elovich | qt = ὰ +ß ln t | ὰ is the initial sorption rate (mg/g/min) and ß is the extent of surface coverage and activation energy for chemisorption (g/mg) |
| Intra-particle diffusion | ki is the intra-particle diffusion rate constant, and ci gives a prediction about the boundary layer thickness |
2.7. Decision Tree Learning Algorithm
2.7.1. Model Validation of DTs
2.7.2. Software and Statistical Procedure
2.8. Characterization of the Biosorption Process
3. Results and Discussion
3.1. Effect of Contact Time
3.2. Effect of Initial Concentration
3.3. Dosage of Biosobants Virsus Cr(VI) Ions Biosorption
3.4. Effect of Solution pH on the Cr(VI) Biosorption
3.5. Biosorption Isotherms
3.6. Biosorption Kinetics
3.7. Decision Tree Learning Algorithm
3.7.1. Selection of DT
3.7.2. Evaluation of the DT Models
3.7.3. Relative Importance of the Variable
3.7.4. Validation of DT Models
3.8. Surface Topology, and Chemistry of the Biosorbents
3.8.1. FT-IR Spectral Analysis
3.8.2. SEM Investigation
3.8.3. EDX Analyses
3.9. Interaction Mechanism of Cr(VI) Ions onto the Biosorbent Particles
4. Conclusions
Supplementary Materials
Author Contributions
Funding
Institutional Review Board Statement
Data Availability Statement
Conflicts of Interest
References
- Tran-Ly, A.N.; Ribera, J.; Schwarze, F.W.; Brunelli, M.; Fortunato, G. Fungal melanin-based electrospun membranes for heavy metal detoxification of water. Sustain. Mater. Technol. 2020, 23, e00146. [Google Scholar] [CrossRef]
- Tchounwou, P.B.; Yedjou, C.G.; Patlolla, A.K.; Sutton, D.J. Heavy metal toxicity and the environment. Mol. Clin. Environ. Toxicol. 2012, 101, 133–164. [Google Scholar]
- Saber, W.I.; El-Naggar, N.E.-A.; El-Hersh, M.S.; El-Khateeb, A.Y.; Elsayed, A.; Eldadamony, N.M.; Ghoniem, A.A. Rotatable central composite design versus artificial neural network for modeling biosorption of Cr6+ by the immobilized Pseudomonas alcaliphila NEWG-2. Sci. Rep. 2021, 11, 1717. [Google Scholar] [CrossRef] [PubMed]
- El-Naggar, N.E.-A.; El-Khateeb, A.Y.; Ghoniem, A.A.; El-Hersh, M.S.; Saber, W.I. Innovative low-cost biosorption process of Cr6+ by Pseudomonas alcaliphila NEWG-2. Sci. Rep. 2020, 10, 14043. [Google Scholar] [CrossRef] [PubMed]
- Samuel, M.S.; Chidambaram, R.J. Hexavalent chromium biosorption studies using Penicillium griseofulvum MSR1 a novel isolate from tannery effluent site: Box–Behnken optimization, equilibrium, kinetics and thermodynamic studies. J. Taiwan Inst. Chem. Eng. 2015, 49, 156–164. [Google Scholar]
- Vafajoo, L.; Cheraghi, R.; Dabbagh, R.; McKay, G. Removal of cobalt (II) ions from aqueous solutions utilizing the pre-treated 2-Hypnea Valentiae algae: Equilibrium, thermodynamic, and dynamic studies. Chem. Eng. J. 2018, 331, 39–47. [Google Scholar] [CrossRef]
- Kapahi, M.; Sachdeva, S.J. Bioremediation options for heavy metal pollution. J. Health Pollut. 2019, 9, 191203. [Google Scholar] [CrossRef]
- Vidal-Cros, A.; Viviani, F.; Labesse, G.; Boccara, M.; Gaudry, M. Polyhydroxynaphthalene reductase involved in melanin biosynthesis in Magnaporthe grisea: Purification, cDNA cloning and sequencing. Eur. J. Biochem. 1994, 219, 985–992. [Google Scholar] [CrossRef] [PubMed]
- Saber, W.I.; Al-Askar, A.A.; Ghoneem, K.M. Exclusive Biosynthesis of Pullulan Using Taguchi’s Approach and Decision Tree Learning Algorithm by a Novel Endophytic Aureobasidium pullulans Strain. Polymers 2023, 15, 1419. [Google Scholar] [CrossRef]
- Pombeiro-Sponchiado, S.R.; Sousa, G.S.; Andrade, J.C.; Lisboa, H.F.; Gonçalves, R. Production of melanin pigment by fungi and its biotechnological applications. Melanin 2017, 1, 47–75. [Google Scholar]
- Seelam, S.D.; Agsar, D.; Shetty, P.R.; Vemireddy, S.; Reddy, K.M.; Umesh, M.; Rajitha, C. Characterization and photoprotective potentiality of lime dwelling Pseudomonas mediated melanin as sunscreen agent against UV-B radiations. J. Photochem. Photobiol. B Biol. 2021, 216, 112126. [Google Scholar] [CrossRef]
- El-Bialy, H.A.; El-Gamal, M.S.; Elsayed, M.A.; Saudi, H.; Khalifa, M. Microbial melanin physiology under stress conditions and gamma radiation protection studies. Radiat. Phys. Chem. 2019, 162, 178–186. [Google Scholar] [CrossRef]
- Brenner, M.; Hearing, V.J. The protective role of melanin against UV damage in human skin. Photochem. Photobiol. 2008, 84, 539–549. [Google Scholar] [CrossRef]
- Kimura, Y.; Sumiyoshi, M.; Kobayashi, T. Whey peptides prevent chronic ultraviolet B radiation–induced skin aging in melanin-possessing male hairless mice. J. Nutr. 2014, 144, 27–32. [Google Scholar] [CrossRef] [PubMed]
- Ribera, J.; Panzarasa, G.; Stobbe, A.; Osypova, A.; Rupper, P.; Klose, D.; Schwarze, F.W. Scalable biosynthesis of melanin by the basidiomycete Armillaria cepistipes. J. Agric. Food Chem. 2018, 67, 132–139. [Google Scholar] [CrossRef] [PubMed]
- Sáiz-Jiménez, C. The chemical nature of the melanins from Coprinus spp. Soil Sci. 1983, 136, 65–74. [Google Scholar] [CrossRef]
- Froncisz, W.; Sarna, T.; Hyde, J.S. Cu2+ probe of metal-ion binding sites in melanin using electron paramagnetic resonance spectroscopy: I. Synthetic melanins. Arch. Biochem. Biophys. 1980, 202, 289–303. [Google Scholar] [CrossRef]
- Saiz-Jimenez, C.; Shafizadeh, F. Iron and copper binding by fungal phenolic polymers: An electron spin resonance study. Curr. Microbiol. 1984, 10, 281–285. [Google Scholar] [CrossRef]
- d’Ischia, M.; Wakamatsu, K.; Napolitano, A.; Briganti, S.; Garcia-Borron, J.C.; Kovacs, D.; Meredith, P.; Pezzella, A.; Picardo, M.; Sarna, T.; et al. Melanins and melanogenesis: Methods, standards, protocols. Pigment. Cell Melanoma Res. 2013, 26, 616–633. [Google Scholar] [CrossRef]
- Hong, L.; Simon, J.D. Current understanding of the binding sites, capacity, affinity, and biological significance of metals in melanin. J. Phys. Chem. B 2007, 111, 7938–7947. [Google Scholar] [CrossRef]
- Felix, C.; Hyde, J.; Sarna, T.; Sealy, R.J. Interactions of melanin with metal ions. Electron. spin resonance evidence for chelate complexes of metal ions with free radicals. J. Am. Chem. Soc. 1978, 100, 3922–3926. [Google Scholar] [CrossRef]
- Buszman, E.; Pilawa, B.; Zdybel, M.; Wilczyński, S.; Gondzik, A.; Witoszyńska, T.; Wilczok, T. EPR examination of Zn2+ and Cu2+ binding by pigmented soil fungi Cladosporium cladosporioides. Sci. Total Environ. 2006, 363, 195–205. [Google Scholar] [CrossRef] [PubMed]
- Oh, J.-J.; Kim, J.Y.; Kim, Y.J.; Kim, S.; Kim, G.-H. Utilization of extracellular fungal melanin as an eco-friendly biosorbent for treatment of metal-contaminated effluents. Chemosphere 2021, 272, 129884. [Google Scholar] [CrossRef] [PubMed]
- Ghosh, S.; Rusyn, I.; Dmytruk, O.V.; Dmytruk, K.V.; Onyeaka, H.; Gryzenhout, M.; Gafforov, Y. Filamentous fungi for sustainable remediation of pharmaceutical compounds, heavy metal and oil hydrocarbons. Front. Bioeng. Biotechnol. 2023, 11, 1106973. [Google Scholar] [CrossRef]
- Dusengemungu, L.; Kasali, G.; Gwanama, C.; Ouma, K.O. Recent Advances in Biosorption of Copper and Cobalt by Filamentous Fungi. Front. Microbiol. 2020, 11, 582016. [Google Scholar] [CrossRef]
- Goodman, K.E.; Lessler, J.; Cosgrove, S.E.; Harris, A.D.; Lautenbach, E.; Han, J.H.; Milstone, A.M.; Massey, C.J.; Tamma, P.D. A clinical decision tree to predict whether a bacteremic patient is infected with an extended-spectrum β-lactamase–producing organism. Clin. Infect. Dis. 2016, 63, 896–903. [Google Scholar] [CrossRef]
- Ashino, K.; Sugano, K.; Amagasa, T.; Ying, B.-W. Predicting the decision making chemicals used for bacterial growth. Sci. Rep. 2019, 9, 7251. [Google Scholar] [CrossRef]
- Giri, D.D.; Shah, M.; Srivastava, N.; Hashem, A.; Abd_Allah, E.F.; Pal, D.B. Sustainable chromium recovery from wastewater using mango and jackfruit seed kernel bio-adsorbents. Front. Microbiol. 2021, 12, 717848. [Google Scholar] [CrossRef]
- He, H.; Lu, Q.; Huang, H.; Xue, F.; Lin, W.; Zhou, H.; Wei, W. Biomass bagasse-based hyperbranched adsorbent for the complete removal of low-level Cr (VI). Cellulose 2020, 27, 8121–8134. [Google Scholar] [CrossRef]
- Rai, R.; Karki, D.R.; Bhattarai, K.P.; Pahari, B.; Shrestha, N.; Adhikari, S.; Gautam, S.K.; Poudel, B.R. Recent advances in biomass-based waste materials for the removal of chromium (VI) from wastewater: A review. Amrit Res. J. 2021, 2, 37–50. [Google Scholar] [CrossRef]
- Li, Q.; Huang, Q.; Pan, X.Y.; Yu, H.; Zhao, Z.T. Adsorption behavior of Cr (VI) by biomass-based adsorbent functionalized with deep eutectic solvents (DESs). BMC Chem. 2022, 16, 41. [Google Scholar] [CrossRef]
- Blaga, A.C.; Zaharia, C.; Suteu, D. Polysaccharides as support for microbial biomass-based adsorbents with applications in removal of heavy metals and dyes. Polymers 2021, 13, 2893. [Google Scholar] [CrossRef] [PubMed]
- Allen, S. Chemical Analysis of Ecological Material; Blackwell Scientific Publications: Oxford, UK, 1974. [Google Scholar]
- Saber, W.I.; Ghoniem, A.A.; Al-Otibi, F.O.; El-Hersh, M.S.; Eldadamony, N.M.; Menaa, F.; Elattar, K.M. A comparative study using response surface methodology and artificial neural network towards optimized production of melanin by Aureobasidium pullulans AKW. Sci. Rep. 2023, 13, 13545. [Google Scholar] [CrossRef]
- El-Gamal, M.; El-Bialy, H.; Elsayed, M.; Khalifa, M. Isolation and characterization of melanized yeast form of Aureobasidium pullulans and physiological studies on the melanization process. J. Nucl. Sci. Technol. 2017, 5, 57–72. [Google Scholar]
- Müjdeci, G.N. Experimental modeling and optimization of melanin production by Aureobasidium pullulans NBRC 100716 in carrot peel extract. Environ. Prog. Sustain. Energy 2022, 41, e13919. [Google Scholar] [CrossRef]
- Şahin, Y.; Öztürk, A. Biosorption of chromium (VI) ions from aqueous solution by the bacterium Bacillus thuringiensis. Process Biochem. 2005, 40, 1895–1901. [Google Scholar] [CrossRef]
- Fakhry, H.; Hassan, H.M.; El-Aassar, M.; Alsohaimi, I.H.; Hussein, M.F.; ALQahtani, M.M.; El-Amier, Y.A. A treatment of wastewater containing Safranin O using immobilized Myriophyllum spicatum L. onto polyacrylonitrile/polyvinylpyrrodlidone biosorbent. J. Inorg. Organomet. Polym. Mater. 2022, 32, 3181–3195. [Google Scholar] [CrossRef]
- El-Amier, Y.A.; Elsayed, A.; El-Esawi, M.A.; Noureldeen, A.; Darwish, H.; Fakhry, H. Optimizing the biosorption behavior of Ludwigia stolonifera in the removal of lead and chromium metal ions from synthetic wastewater. Sustainability 2021, 13, 6390. [Google Scholar] [CrossRef]
- Cheng, Q.; Fang, Z.; Yi, X.S.; An, X.; Tang, B.; Xu, Y. “Ex situ” concept for toughening the RTMable BMI matrix composites, Part I: Improving the interlaminar fracture toughness. J. Appl. Polym. Sci. 2008, 109, 1625–1634. [Google Scholar] [CrossRef]
- Ho, Y.-S.; McKay, G. Pseudo-second order model for sorption processes. Process Biochem. 1999, 34, 451–465. [Google Scholar] [CrossRef]
- Priya, A.; Yogeshwaran, V.; Rajendran, S.; Hoang, T.K.; Soto-Moscoso, M.; Ghfar, A.A.; Bathula, C. Investigation of mechanism of heavy metals (Cr6+, Pb2+ & Zn2+) adsorption from aqueous medium using rice husk ash: Kinetic and thermodynamic approach. Chemosphere 2022, 286, 131796. [Google Scholar]
- Fakhry, H.; El-Sonbati, M.; Omar, B.; El-Henawy, R.; Zhang, Y.; Marwa, E.-K. Novel fabricated low-cost hybrid polyacrylonitrile/polyvinylpyrrolidone coated polyurethane foam (PAN/PVP@ PUF) membrane for the decolorization of cationic and anionic dyes. J. Environ. Manag. 2022, 315, 115128. [Google Scholar] [CrossRef] [PubMed]
- Sivashankar, R.; Sathya, A.; Kanimozhi, J.; Deepanraj, B. Characterization of the biosorption process. In Biosorption for Wastewater Contaminants; Wiley: Hoboken, NJ, USA, 2022; pp. 102–116. [Google Scholar]
- Wang, H.; Ren, Z.J. Bioelectrochemical metal recovery from wastewater: A review. Water Res. 2014, 66, 219–232. [Google Scholar] [CrossRef]
- Bolisetty, S.; Peydayesh, M.; Mezzenga, R. Sustainable technologies for water purification from heavy metals: Review and analysis. Chem. Soc. Rev. 2019, 48, 463–487. [Google Scholar] [CrossRef]
- Hong, L.; Liu, Y.; Simon, J.D. Binding of metal ions to melanin and their effects on the aerobic reactivity. Photochem. Photobiol. 2004, 80, 477–481. [Google Scholar] [CrossRef] [PubMed]
- Zubair, A.; Bhatti, H.N.; Hanif, M.A.; Shafqat, F. Kinetic and equilibrium modeling for Cr (III) and Cr (VI) removal from aqueous solutions by Citrus reticulata waste biomass. Water Air Soil Pollut. 2008, 191, 305–318. [Google Scholar] [CrossRef]
- Sibi, G. Biosorption of chromium from electroplating and galvanizing industrial effluents under extreme conditions using Chlorella vulgaris. Green. Energy Environ. 2016, 1, 172–177. [Google Scholar] [CrossRef]
- Rezaei, H. Biosorption of chromium by using Spirulina sp. Arab. J. Chem. 2016, 9, 846–853. [Google Scholar] [CrossRef]
- Kanchana, S.; Jeyanthi, J.; Kumar, R.D. Equilibrium and kinetic studies on biosorption of chromium (VI) on to Chlorella species. Eur. J. Sci. Res. 2011, 63, 255–262. [Google Scholar]
- Marandi, R. Biosorption of hexavalent chromium from aqueous solution by dead fungal biomass of Phanerochaete crysosporium: Batch and fixed bed studies. Can. J. Chem. Eng. Technol. 2011, 2, 8–22. [Google Scholar]
- Suganya, E.; Saranya, N.; Patra, C.; Varghese, L.A.; Selvaraju, N. Biosorption potential of Gliricidia sepium leaf powder to sequester hexavalent chromium from synthetic aqueous solution. J. Environ. Chem. Eng. 2019, 7, 103112. [Google Scholar]
- Nakkeeran, E.; Patra, C.; Shahnaz, T.; Rangabhashiyam, S.; Selvaraju, N. Continuous biosorption assessment for the removal of hexavalent chromium from aqueous solutions using Strychnos nux vomica fruit shell. Bioresour. Technol. Rep. 2018, 3, 256–260. [Google Scholar] [CrossRef]
- Mangwandi, C.; Kurniawan, T.A.; Albadarin, A.B. Comparative biosorption of chromium (VI) using chemically modified date pits (CM-DP) and olive stone (CM-OS): Kinetics, isotherms and influence of co-existing ions. Chem. Eng. Res. Des. 2020, 156, 251–262. [Google Scholar] [CrossRef]
- Roșca, M.; Silva, B.; Tavares, T.; Gavrilescu, M. Biosorption of Hexavalent Chromium by Bacillus megaterium and Rhodotorula sp. Inact. Biomass. Process. 2023, 11, 179. [Google Scholar]
- Bhatti, H.N.; Khalid, R.; Hanif, M.A. Dynamic biosorption of Zn (II) and Cu (II) using pretreated Rosa gruss an teplitz (red rose) distillation sludge. Chem. Eng. J. 2009, 148, 434–443. [Google Scholar] [CrossRef]
- Wang, G.; Zhang, S.; Yao, P.; Chen, Y.; Xu, X.; Li, T.; Gong, G. Removal of Pb (II) from aqueous solutions by Phytolacca americana L. biomass as a low cost biosorbent. Arab. J. Chem. 2018, 11, 99–110. [Google Scholar]
- Naseem, K.; Farooqi, Z.H.; Begum, R.; Rehman, M.Z.U.; Shahbaz, A.; Farooq, U.; Ali, M.; Rahman, H.M.A.U.; Irfan, A.; Al-Sehemi, A.G. Removal of cadmium (II) from aqueous medium using vigna radiata leave biomass: Equilibrium isotherms, kinetics and thermodynamics. Z. Für Phys. Chem. 2019, 233, 669–690. [Google Scholar] [CrossRef]
- Ume, O.L.; Ekeoma, B.C.; Yusuf, M.; Al-Kahtani, A.A.; Ubaidullah, M.; Sillanpää, M. Batch studies of hexavalent chromium biosorption from mining wastewater using Aspergillus niger. Results Chem. 2022, 4, 100490. [Google Scholar] [CrossRef]
- Miretzky, P.; Cirelli, A.F. Cr(VI) and Cr(III) removal from aqueous solution by raw and modified lignocellulosic materials: A review. J. Hazard. Mater. 2010, 180, 1–19. [Google Scholar] [CrossRef]
- Krishna Kumar, A.S.; Warchol, J.; Matusik, J.; Tseng, W.-L.; Rajesh, N.; Bajda, T. Heavy metal and organic dye removal via a hybrid porous hexagonal boron nitride-based magnetic aerogel. NPJ Clean. Water 2022, 5, 24. [Google Scholar] [CrossRef]
- Jobby, R.; Jha, P.; Gupta, A.; Gupte, A.; Desai, N. Biotransformation of chromium by root nodule bacteria Sinorhizobium sp. SAR1. PLoS ONE 2019, 14, e0219387. [Google Scholar] [CrossRef]
- da Rocha Ferreira, G.L.; Vendruscolo, F.; Antoniosi Filho, N.R. Biosorption of hexavalent chromium by Pleurotus ostreatus. Heliyon 2019, 5, e01450. [Google Scholar] [CrossRef] [PubMed]
- Pradhan, D.; Sukla, L.B.; Mishra, B.B.; Devi, N. Biosorption for removal of hexavalent chromium using microalgae Scenedesmus sp. J. Clean. Prod. 2019, 209, 617–629. [Google Scholar] [CrossRef]
- Manzoor, Q.; Nadeem, R.; Iqbal, M.; Saeed, R.; Ansari, T.M. Organic acids pretreatment effect on Rosa bourbonia phyto-biomass for removal of Pb (II) and Cu (II) from aqueous media. Bioresour. Technol. 2013, 132, 446–452. [Google Scholar] [CrossRef] [PubMed]
- El-Aassar, M.; Ibrahim, O.M.; Omar, B.M.; El-Hamid, H.T.A.; Alsohaim, I.H.; Hassan, H.M.; Althobaiti, I.O.; El-Sayed, M.Y.; Goher, M.E.; Fakhry, H. Hybrid Beads of Poly (Acrylonitrile-co-Styrene/Pyrrole)@ Poly Vinyl Pyrrolidone for Removing Carcinogenic Methylene Blue Dye Water Pollutant. J. Polym. Environ. 2023, 31, 2912–2929. [Google Scholar] [CrossRef]
- Omar, B.M.; Abdelgalil, S.A.; Fakhry, H.; Tamer, T.M.; El-Sonbati, M.A. Wheat husk-based sorbent as an economical solution for removal of oil spills from sea water. Sci. Rep. 2023, 13, 2575. [Google Scholar] [CrossRef]
- Gupta, V.; Rastogi, A. Biosorption of hexavalent chromium by raw and acid-treated green alga Oedogonium hatei from aqueous solutions. J. Hazard. Mater. 2009, 163, 396–402. [Google Scholar] [CrossRef]
- Bulgariu, L.; Bulgariu, D.; Rusu, C. Marine algae biomass for removal of heavy metal ions. In Springer Handbook of Marine Biotechnology; Springer: Berlin/Heidelberg, Germany, 2015; pp. 611–648. [Google Scholar]
- Shamim, S. Biosorption of heavy metals. Biosorption 2018, 2, 21–49. [Google Scholar]
- Pagnanelli, F. Equilibrium, kinetic and dynamic modelling of biosorption processes. In Microbial Biosorption of Metals; Springer: Dordrecht, The Netherlands, 2011; pp. 59–120. [Google Scholar]
- Roşca, M.; Hlihor, R.M.; Cozma, P.; Simion, I.M.; Filote, C.; Grecu, C.; Stoleru, V.; Gavrilescu, M. Scaling-Up Strategies of Heavy Metals Microbial Bioremediation. In Proceedings of the 2021 International Conference on e-Health and Bioengineering (EHB), Iasi, Romania, 18–19 November 2021; pp. 1–4. [Google Scholar]
- Li, X.; Xu, Q.; Han, G.; Zhu, W.; Chen, Z.; He, X.; Tian, X. Equilibrium and kinetic studies of copper (II) removal by three species of dead fungal biomasses. J. Hazard. Mater. 2009, 165, 469–474. [Google Scholar] [CrossRef]
- Taty-Costodes, V.C.; Fauduet, H.; Porte, C.; Delacroix, A. Removal of Cd (II) and Pb (II) ions, from aqueous solutions, by adsorption onto sawdust of Pinus sylvestris. J. Hazard. Mater. 2003, 105, 121–142. [Google Scholar] [CrossRef]
- Yan, C.-Z.; Wang, S.-R.; Zeng, A.-Y.; Jin, X.-C.; Xu, Q.-J.; Zhao, J.-Z. Equilibrium and kinetics of copper (II) biosorption by Myriophyllum spicatum L. J. Environ. Sci. 2005, 17, 1025–1029. [Google Scholar]
- Masinga, T.; Moyo, M.; Pakade, V.E. Removal of hexavalent chromium by polyethyleneimine impregnated activated carbon: Intra-particle diffusion, kinetics and isotherms. J. Mater. Res. Technol. 2022, 18, 1333–1344. [Google Scholar] [CrossRef]
- Cuong, A.M.; Le Na, N.T.; Thang, P.N.; Diep, T.N.; Thuy, L.B.; Thanh, N.L.; Thang, N.D. Melanin-embedded materials effectively remove hexavalent chromium (CrVI) from aqueous solution. Environ. Health Prev. Med. 2018, 23, 9. [Google Scholar] [CrossRef] [PubMed]
- Manirethan, V.; Raval, K.; Rajan, R.; Thaira, H.; Balakrishnan, R.M. Kinetic and thermodynamic studies on the adsorption of heavy metals from aqueous solution by melanin nanopigment obtained from marine source: Pseudomonas stutzeri. J. Environ. Manag. 2018, 214, 315–324. [Google Scholar] [CrossRef] [PubMed]
- Ghoniem, A.A.; Moussa, Z.; Alenzi, A.M.; Alotaibi, A.S.; Fakhry, H.; El-Khateeb, A.Y.; Saber, W.I.; Elsayed, A. Pseudomonas alcaliphila NEWG-2 as biosorbent agent for methylene blue dye: Optimization, equilibrium isotherms, and kinetic processes. Sci. Rep. 2023, 13, 3678. [Google Scholar] [CrossRef]
- Sajjan, S.S.; Anjaneya, O.; Kulkarni, G.B.; Nayak, A.S.; Mashetty, S.B.; Karegoudar, T.B. Properties and Functions of Melanin Pigment from Klebsiella sp. GSK. Korean J. Microbiol. Biotechnol. 2013, 41, 60–69. [Google Scholar] [CrossRef]
- Kalidhasan, S.; Gupta, P.A.; Cholleti, V.R.; Kumar, A.S.K.; Rajesh, V.; Rajesh, N. Microwave assisted solvent free green preparation and physicochemical characterization of surfactant-anchored cellulose and its relevance toward the effective adsorption of chromium. J. Colloid Interface Sci. 2012, 372, 88–98. [Google Scholar] [CrossRef] [PubMed]
- Kalidhasan, S.; Kumar, A.S.K.; Rajesh, V.; Rajesh, N. Enhanced adsorption of hexavalent chromium arising out of an admirable interaction between a synthetic polymer and an ionic liquid. Chem. Eng. J. 2013, 222, 454–463. [Google Scholar] [CrossRef]
- Liao, L.F.; Lien, C.F.; Shieh, D.L.; Chen, M.T.; Lin, J.L. FTIR Study of Adsorption and Photoassisted Oxygen Isotopic Exchange of Carbon Monoxide, Carbon Dioxide, Carbonate, and Formate on TiO2. J. Phys. Chem. B 2002, 106, 11240–11245. [Google Scholar] [CrossRef]
- Chen, A.; Zeng, G.; Chen, G.; Liu, L.; Shang, C.; Hu, X.; Lu, L.; Chen, M.; Zhou, Y.; Zhang, Q. Plasma membrane behavior, oxidative damage, and defense mechanism in Phanerochaete chrysosporium under cadmium stress. Process Biochem. 2014, 49, 589–598. [Google Scholar] [CrossRef]
- Gururajan, K.; Belur, P.D. Screening and selection of indigenous metal tolerant fungal isolates for heavy metal removal. Environ. Technol. Innov. 2018, 9, 91–99. [Google Scholar] [CrossRef]
- Simon, J.D.; Peles, D.; Wakamatsu, K.; Ito, S. Current challenges in understanding melanogenesis: Bridging chemistry, biological control, morphology, and function. Pigment Cell Melanoma Res. 2009, 22, 563–579. [Google Scholar] [CrossRef] [PubMed]
- Biswas, S.; Mishra, U. Continuous Fixed-Bed Column Study and Adsorption Modeling: Removal of Lead Ion from Aqueous Solution by Charcoal Originated from Chemical Carbonization of Rubber Wood Sawdust. J. Chem. 2015, 2015, 907379. [Google Scholar] [CrossRef]
- Manirethan, V.; Gupta, N.; Balakrishnan, R.M.; Raval, K. Batch and continuous studies on the removal of heavy metals from aqueous solution using biosynthesised melanin-coated PVDF membranes. Environ. Sci. Pollut. Res. 2020, 27, 24723–24737. [Google Scholar] [CrossRef]
- Rizvi, A.; Ahmed, B.; Zaidi, A.; Khan, M.S. Bioreduction of toxicity influenced by bioactive molecules secreted under metal stress by Azotobacter chroococcum. Ecotoxicology 2019, 28, 302–322. [Google Scholar] [CrossRef]

| Adsorption Models | Equation | Parameter |
|---|---|---|
| Langmuir | qe is the amount of Cr(VI) ions biosorbent at equilibrium (mg/g), qm is the supreme monolayer coverage aptitudes (mg/g), K is the Langmuir constant (L/mg), and Ce is the equilibrium concentration of Cr(VI) ions (mg/L). | |
| Freundlich | qe is the Cr (VI) ions amount biosorbent at equilibrium (mg/g); Ce is the Cr (VI) ions equilibrium concentration (mg/L); and KF and nf are Freundlich constants related to the biosorption aptitude and biosorption intensity, respectively | |
| Temkin | qe = B ln KT + B ln Ce | KT is the Temkin constant referring to equilibrium maximum binding energy and B is the Temkin constant interrelated to bio-sorption heat. |
| Isotherm Parameters | Fungal Biomass | Melanin |
|---|---|---|
| Langmuir | ||
| qm (mg g−1) calculated | 485.747 | 595.974 |
| KL (mg L−1) | 0.034 | 0.042 |
| R2 | 0.976 | 0.986 |
| Freundlich | ||
| KF (mgL−1/n L1/n g−1) | 24.395 | 1.907 |
| Nf | 1.64 | 1.55 |
| R2 | 0.956 | 0.959 |
| Temkin B (mg L−1) | 90.189 | 117.017 |
| KT (KJ mol−1) | 0.637 | 0.693 |
| R2 | 0.967 | 0.969 |
| Kinetic Model | Fungal Biomass | Melanin | |
|---|---|---|---|
| Pseudo-first-order | qe (mg/g) Calculated | 69.4148 | 163.531 |
| qe (mg/g) Experimental | 62.9 | 86.400 | |
| k1 (min−1) | −0.015 | 0.015 | |
| R2 | 0.774 | 0.707 | |
| Pseudo-second-order | qe (mg/g) Calculated | 85.825 | 107.704 |
| qe (mg/g) Experimental | 62.9 | 86.400 | |
| k2 (g/mg min) | 0.01 | 0.0048 | |
| R2 | 0.678 | 0.235 | |
| Elovich | ß (g/mg) | 15.137 | 21.853 |
| ὰ (mg/g min) | −32.062 | −60.041 | |
| R2 | 0.820 | 0.692 | |
| Intra-particle diffusion | K1, | 3.888 | 5.748 |
| C1 | −5.933 | −23.697 | |
| R2 | 0.900 | 0.844 | |
| Adsorbent | qm (mg/g) | Reference |
|---|---|---|
| Fungal biomass and melanin | 485.747 and 595.974 | Current study |
| Removal of Cr(VI) by polyethyleneimine-impregnated activated carbon | 114 | [77] |
| Biosorption of chromium metal ions onto Ludwigia stolonifera | 43.478 | [39] |
| Biosorption of Cr(VI) by Bacillus megaterium and Rhodotorula sp. inactivated biomass | 34.80 | [56] |
| Melanin-embedded materials effectively remove Cr(VI) | 19.60 and 6.24 for IMB and CMB | [78] |
| Melanin nano pigment from Pseudomonas stutzeri | 126.9 | [79] |
| Equilibrium and kinetic studies of copper(II) removal by fungal biomasses | 7.74 and 12.08 | [74] |
| Isotherm or Kinetic Test | Run | Tested Parameter | Cr(VI) Removal, % | ||||||||
|---|---|---|---|---|---|---|---|---|---|---|---|
| Actual | Decision Tree | ||||||||||
| Time, min | Cr(VI), mg/mL | Biomass (g/100 mL) | pH | Value | Mean | Type | Fitted | Error | Terminal Node | ||
| Contact time | 1 | 10 | 10 | 0.010 | 5 | 13.44 | 13.46 ± 0.11 | Test | 14.64 | −1.20 | 1 |
| 2 | 20 | 10 | 0.010 | 5 | 15.41 | 15.25 ± 0.14 | Test | 14.64 | 0.77 | 1 | |
| 3 | 30 | 10 | 0.010 | 5 | 17.88 | 17.87 ± 0.07 | Training | 17.87 | 0.01 | 2 | |
| 4 | 60 | 10 | 0.010 | 5 | 19.35 | 19.56 ± 0.19 | Test | 20.69 | −1.34 | 3 | |
| 5 | 120 | 10 | 0.010 | 5 | 21.11 | 21.24 ± 0.15 | Training | 20.69 | 0.42 | 3 | |
| 6 | 180 | 10 | 0.010 | 5 | 29.23 | 30.35 ± 1.15 | Test | 30.31 | −1.08 | 4 | |
| 7 | 240 | 10 | 0.010 | 5 | 53.00 | 54.02 ± 1.01 | Training | 59.48 | −6.48 | 9 | |
| 8 | 280 | 10 | 0.010 | 5 | 62.50 | 62.99 ± 0.72 | Test | 62.65 | −0.15 | 10 | |
| 9 | 300 | 10 | 0.010 | 5 | 70.95 | 71.82 ± 1.03 | Training | 71.25 | −0.30 | 13 | |
| Initial Cr(VI) | 10 | 240 | 5 | 0.010 | 5 | 68.25 | 69.45 ± 1.05 | Training | 69.45 | −1.19 | 8 |
| 11 | 240 | 10 | 0.010 | 5 | 53.34 | 54.08 ± 0.79 | Training | 59.48 | −6.15 | 9 | |
| 12 | 240 | 50 | 0.010 | 5 | 50.45 | 51.70 ± 1.21 | Test | 52.32 | −1.86 | 11 | |
| 13 | 240 | 100 | 0.010 | 5 | 35.96 | 36.87 ± 1.03 | Test | 25.24 | 10.72 | 16 | |
| 14 | 240 | 200 | 0.010 | 5 | 19.43 | 20.03 ± 0.86 | Training | 25.24 | −5.81 | 16 | |
| Melanin | 15 | 240 | 10 | 0.005 | 5 | 33.04 | 33.05 ± 0.99 | Training | 33.05 | −0.01 | 5 |
| 16 | 240 | 10 | 0.010 | 5 | 50.84 | 50.61 ± 0.65 | Training | 59.48 | −8.64 | 9 | |
| 17 | 240 | 10 | 0.050 | 5 | 59.54 | 60.26 ± 0.81 | Training | 59.48 | 0.06 | 9 | |
| 18 | 240 | 10 | 0.100 | 5 | 71.59 | 72.33 ± 0.92 | Training | 72.33 | −0.74 | 14 | |
| 19 | 240 | 10 | 0.200 | 5 | 85.32 | 85.58 ± 0.86 | Training | 85.58 | −0.26 | 15 | |
| pH | 20 | 240 | 10 | 0.010 | 2 | 98.25 | 98.16 ± 0.94 | Test | 99.04 | −0.78 | 6 |
| 21 | 240 | 10 | 0.010 | 4 | 82.88 | 83.67 ± 0.69 | Training | 83.67 | −0.79 | 7 | |
| 22 | 240 | 10 | 0.010 | 5 | 79.32 | 79.16 ± 1.06 | Test | 59.48 | 19.84 | 9 | |
| 23 | 240 | 10 | 0.010 | 7 | 52.32 | 52.19 ± 0.89 | Test | 52.13 | 0.19 | 12 | |
| 24 | 240 | 10 | 0.010 | 9 | 23.87 | 24.61 ± 0.73 | Test | 24.65 | −0.78 | 17 | |
| 25 | 240 | 10 | 0.010 | 11 | 6.53 | 6.65 ± 0.30 | Training | 6.65 | −0.11 | 18 | |
| Contact time | 1 | 10 | 10 | 0.010 | 5 | 13.36 | Test | 14.64 | −1.28 | 1 | |
| 2 | 20 | 10 | 0.010 | 5 | 15.15 | Training | 14.64 | 0.51 | 1 | ||
| 3 | 30 | 10 | 0.010 | 5 | 17.94 | Training | 17.87 | 0.07 | 2 | ||
| 4 | 60 | 10 | 0.010 | 5 | 19.73 | Training | 20.69 | −0.96 | 3 | ||
| 5 | 120 | 10 | 0.010 | 5 | 21.22 | Training | 20.69 | 0.53 | 3 | ||
| 6 | 180 | 10 | 0.010 | 5 | 31.52 | Test | 30.31 | 1.21 | 4 | ||
| 7 | 240 | 10 | 0.010 | 5 | 54.04 | Test | 59.48 | −5.44 | 9 | ||
| 8 | 280 | 10 | 0.010 | 5 | 62.65 | Training | 62.65 | 0.00 | 10 | ||
| 9 | 300 | 10 | 0.010 | 5 | 72.97 | Test | 71.25 | 1.71 | 13 | ||
| Initial Cr(VI) | 10 | 240 | 5 | 0.010 | 5 | 69.88 | Training | 69.45 | 0.43 | 8 | |
| 11 | 240 | 10 | 0.010 | 5 | 54.92 | Training | 59.48 | −4.56 | 9 | ||
| 12 | 240 | 50 | 0.010 | 5 | 51.77 | Training | 52.32 | −0.55 | 11 | ||
| 13 | 240 | 100 | 0.010 | 5 | 37.99 | Test | 25.24 | 12.74 | 16 | ||
| 14 | 240 | 200 | 0.010 | 5 | 19.64 | Training | 25.24 | −5.60 | 16 | ||
| Melanin | 15 | 240 | 10 | 0.005 | 5 | 32.07 | Training | 33.05 | −0.99 | 5 | |
| 16 | 240 | 10 | 0.010 | 5 | 49.88 | Training | 59.48 | −9.61 | 9 | ||
| 17 | 240 | 10 | 0.050 | 5 | 60.09 | Test | 59.48 | 0.61 | 9 | ||
| 18 | 240 | 10 | 0.100 | 5 | 72.03 | Training | 72.33 | −0.29 | 14 | ||
| 19 | 240 | 10 | 0.200 | 5 | 84.88 | Training | 85.58 | −0.70 | 15 | ||
| pH | 20 | 240 | 10 | 0.010 | 2 | 97.17 | Test | 99.04 | −1.86 | 6 | |
| 21 | 240 | 10 | 0.010 | 4 | 83.99 | Training | 83.67 | 0.32 | 7 | ||
| 22 | 240 | 10 | 0.010 | 5 | 78.03 | Training | 59.48 | 18.55 | 9 | ||
| 23 | 240 | 10 | 0.010 | 7 | 51.25 | Training | 52.13 | −0.88 | 12 | ||
| 24 | 240 | 10 | 0.010 | 9 | 24.65 | Training | 24.65 | 0.00 | 17 | ||
| 25 | 240 | 10 | 0.010 | 11 | 6.42 | Training | 6.65 | −0.22 | 18 | ||
| Contact time | 1 | 10 | 10 | 0.010 | 5 | 13.58 | Training | 14.64 | −1.06 | 1 | |
| 2 | 20 | 10 | 0.010 | 5 | 15.20 | Training | 14.64 | 0.56 | 1 | ||
| 3 | 30 | 10 | 0.010 | 5 | 17.79 | Training | 17.87 | −0.07 | 2 | ||
| 4 | 60 | 10 | 0.010 | 5 | 19.60 | Test | 20.69 | −1.09 | 3 | ||
| 5 | 120 | 10 | 0.010 | 5 | 21.40 | Test | 20.69 | 0.71 | 3 | ||
| 6 | 180 | 10 | 0.010 | 5 | 30.31 | Training | 30.31 | 0.00 | 4 | ||
| 7 | 240 | 10 | 0.010 | 5 | 55.02 | Test | 59.48 | −4.46 | 9 | ||
| 8 | 280 | 10 | 0.010 | 5 | 63.81 | Test | 62.65 | 1.16 | 10 | ||
| 9 | 300 | 10 | 0.010 | 5 | 71.55 | Training | 71.25 | 0.30 | 13 | ||
| Initial Cr(VI) | 10 | 240 | 5 | 0.010 | 5 | 70.21 | Training | 69.45 | 0.77 | 8 | |
| 11 | 240 | 10 | 0.010 | 5 | 54.00 | Training | 59.48 | −5.48 | 9 | ||
| 12 | 240 | 50 | 0.010 | 5 | 52.86 | Training | 52.32 | 0.55 | 11 | ||
| 13 | 240 | 100 | 0.010 | 5 | 36.65 | Training | 25.24 | 11.41 | 16 | ||
| 14 | 240 | 200 | 0.010 | 5 | 21.02 | Test | 25.24 | −4.22 | 16 | ||
| Melanin | 15 | 240 | 10 | 0.005 | 5 | 34.04 | Training | 33.05 | 0.99 | 5 | |
| 16 | 240 | 10 | 0.010 | 5 | 51.12 | Test | 59.48 | −8.36 | 9 | ||
| 17 | 240 | 10 | 0.050 | 5 | 61.13 | Training | 59.48 | 1.65 | 9 | ||
| 18 | 240 | 10 | 0.100 | 5 | 73.35 | Training | 72.33 | 1.03 | 14 | ||
| 19 | 240 | 10 | 0.200 | 5 | 86.54 | Training | 85.58 | 0.96 | 15 | ||
| pH | 20 | 240 | 10 | 0.010 | 2 | 99.04 | Training | 99.04 | 0.00 | 6 | |
| 21 | 240 | 10 | 0.010 | 4 | 84.14 | Training | 83.67 | 0.47 | 7 | ||
| 22 | 240 | 10 | 0.010 | 5 | 80.13 | Training | 59.48 | 20.65 | 9 | ||
| 23 | 240 | 10 | 0.010 | 7 | 53.02 | Training | 52.13 | 0.88 | 12 | ||
| 24 | 240 | 10 | 0.010 | 9 | 25.32 | Test | 24.65 | 0.67 | 17 | ||
| 25 | 240 | 10 | 0.010 | 11 | 6.99 | Training | 6.65 | 0.34 | 18 | ||
| Isotherm or Kinetic Test | Run | Tested Parameters | Cr(VI) Removal, % | ||||||||
|---|---|---|---|---|---|---|---|---|---|---|---|
| Actual | Decision Tree | ||||||||||
| No. | Time, min | Cr(VI), mg/mL | Melanin (g/100 mL) | pH | Value | Mean | Type | Fitted | Error | Terminal Node | |
| Contact time | 1 | 10 | 10 | 0.010 | 5 | 9.95 | 9.84 ± 0.14 | Test | 10.05 | −0.10 | 1 |
| 2 | 20 | 10 | 0.010 | 5 | 9.32 | 9.46 ± 0.24 | Test | 10.05 | −0.73 | 1 | |
| 3 | 30 | 10 | 0.010 | 5 | 10.45 | 10.09 ± 0.45 | Training | 10.05 | 0.40 | 1 | |
| 4 | 60 | 10 | 0.010 | 5 | 10.36 | 10.13 ± 0.49 | Test | 10.05 | 0.31 | 1 | |
| 5 | 120 | 10 | 0.010 | 5 | 10.73 | 10.11 ± 0.59 | Training | 10.05 | 0.68 | 1 | |
| 6 | 180 | 10 | 0.010 | 5 | 22.21 | 23.14 ± 0.93 | Test | 23.14 | −0.92 | 2 | |
| 7 | 240 | 10 | 0.010 | 5 | 68.23 | 69.40 ± 1.16 | Training | 64.91 | 3.32 | 5 | |
| 8 | 280 | 10 | 0.010 | 5 | 84.55 | 86.41 ± 1.79 | Test | 89.07 | −4.52 | 6 | |
| 9 | 300 | 10 | 0.010 | 5 | 89.05 | 90.04 ± 0.99 | Training | 89.07 | −0.02 | 6 | |
| Initial Cr(VI) | 10 | 240 | 5 | 0.010 | 5 | 70.12 | 70.39 ± 0.95 | Training | 64.91 | 5.21 | 5 |
| 11 | 240 | 10 | 0.010 | 5 | 57.18 | 58.14 ± 0.97 | Training | 64.91 | −7.73 | 5 | |
| 12 | 240 | 50 | 0.010 | 5 | 61.49 | 61.72 ± 0.88 | Test | 64.91 | −3.42 | 5 | |
| 13 | 240 | 100 | 0.010 | 5 | 48.88 | 48.91 ± 0.94 | Test | 33.33 | 15.55 | 8 | |
| 14 | 240 | 200 | 0.010 | 5 | 26.00 | 25.05 ± 0.95 | Training | 33.33 | −7.33 | 8 | |
| Melanin | 15 | 240 | 10 | 0.005 | 5 | 30.20 | 30.56 ± 1.21 | Training | 30.56 | −0.36 | 3 |
| 16 | 240 | 10 | 0.010 | 5 | 52.22 | 52.28 ± 0.91 | Training | 64.91 | −12.69 | 5 | |
| 17 | 240 | 10 | 0.050 | 5 | 66.95 | 66.96 ± 1.00 | Training | 64.91 | 2.04 | 5 | |
| 18 | 240 | 10 | 0.100 | 5 | 83.90 | 83.77 ± 0.95 | Training | 86.75 | −2.85 | 7 | |
| 19 | 240 | 10 | 0.200 | 5 | 89.65 | 89.73 ± 0.89 | Training | 86.75 | 2.90 | 7 | |
| pH | 20 | 240 | 10 | 0.010 | 2 | 98.76 | 98.83 ± 0.98 | Test | 95.36 | 3.40 | 4 |
| 21 | 240 | 10 | 0.010 | 4 | 93.88 | 93.87 ± 0.90 | Training | 95.36 | −1.49 | 4 | |
| 22 | 240 | 10 | 0.010 | 5 | 77.69 | 77.82 ± 0.92 | Test | 64.91 | 12.78 | 5 | |
| 23 | 240 | 10 | 0.010 | 7 | 65.12 | 65.59 ± 1.02 | Test | 64.91 | 0.21 | 5 | |
| 24 | 240 | 10 | 0.010 | 9 | 40.25 | 40.21 ± 0.98 | Test | 41.18 | −0.93 | 9 | |
| 25 | 240 | 10 | 0.010 | 11 | 24.85 | 24.83 ± 1.06 | Training | 24.83 | 0.02 | 10 | |
| Contact time | 1 | 10 | 10 | 0.010 | 5 | 9.68 | Test | 10.05 | −0.37 | 1 | |
| 2 | 20 | 10 | 0.010 | 5 | 9.73 | Training | 10.05 | −0.32 | 1 | ||
| 3 | 30 | 10 | 0.010 | 5 | 10.23 | Training | 10.05 | 0.18 | 1 | ||
| 4 | 60 | 10 | 0.010 | 5 | 10.45 | Training | 10.05 | 0.40 | 1 | ||
| 5 | 120 | 10 | 0.010 | 5 | 10.06 | Training | 10.05 | 0.01 | 1 | ||
| 6 | 180 | 10 | 0.010 | 5 | 24.07 | Test | 23.14 | 0.94 | 2 | ||
| 7 | 240 | 10 | 0.010 | 5 | 69.42 | Test | 64.91 | 4.51 | 5 | ||
| 8 | 280 | 10 | 0.010 | 5 | 88.12 | Training | 89.07 | −0.95 | 6 | ||
| 9 | 300 | 10 | 0.010 | 5 | 91.03 | Test | 89.07 | 1.96 | 6 | ||
| Initial Cr(VI) | 10 | 240 | 5 | 0.010 | 5 | 71.46 | Training | 64.91 | 6.55 | 5 | |
| 11 | 240 | 10 | 0.010 | 5 | 58.13 | Training | 64.91 | −6.78 | 5 | ||
| 12 | 240 | 50 | 0.010 | 5 | 60.98 | Training | 64.91 | −3.93 | 5 | ||
| 13 | 240 | 100 | 0.010 | 5 | 47.99 | Test | 33.33 | 14.66 | 8 | ||
| 14 | 240 | 200 | 0.010 | 5 | 24.11 | Training | 33.33 | −9.22 | 8 | ||
| Melanin | 15 | 240 | 10 | 0.005 | 5 | 31.91 | Training | 30.56 | 1.35 | 3 | |
| 16 | 240 | 10 | 0.010 | 5 | 51.40 | Training | 64.91 | −13.51 | 5 | ||
| 17 | 240 | 10 | 0.050 | 5 | 65.97 | Test | 64.91 | 1.06 | 5 | ||
| 18 | 240 | 10 | 0.100 | 5 | 82.77 | Training | 86.75 | −3.98 | 7 | ||
| 19 | 240 | 10 | 0.200 | 5 | 88.88 | Training | 86.75 | 2.13 | 7 | ||
| pH | 20 | 240 | 10 | 0.010 | 2 | 97.89 | Test | 95.36 | 2.53 | 4 | |
| 21 | 240 | 10 | 0.010 | 4 | 92.97 | Training | 95.36 | −2.40 | 4 | ||
| 22 | 240 | 10 | 0.010 | 5 | 78.79 | Training | 64.91 | 13.88 | 5 | ||
| 23 | 240 | 10 | 0.010 | 7 | 66.77 | Training | 64.91 | 1.86 | 5 | ||
| 24 | 240 | 10 | 0.010 | 9 | 41.18 | Training | 41.18 | 0.00 | 9 | ||
| 25 | 240 | 10 | 0.010 | 11 | 25.88 | Training | 24.83 | 1.04 | 10 | ||
| Contact time | 1 | 10 | 10 | 0.010 | 5 | 9.88 | Training | 10.05 | −0.18 | 1 | |
| 2 | 20 | 10 | 0.010 | 5 | 9.33 | Training | 10.05 | −0.72 | 1 | ||
| 3 | 30 | 10 | 0.010 | 5 | 9.58 | Training | 10.05 | −0.47 | 1 | ||
| 4 | 60 | 10 | 0.010 | 5 | 9.57 | Test | 10.05 | −0.49 | 1 | ||
| 5 | 120 | 10 | 0.010 | 5 | 9.54 | Test | 10.05 | −0.51 | 1 | ||
| 6 | 180 | 10 | 0.010 | 5 | 23.14 | Training | 23.14 | 0.00 | 2 | ||
| 7 | 240 | 10 | 0.010 | 5 | 70.54 | Test | 64.91 | 5.63 | 5 | ||
| 8 | 280 | 10 | 0.010 | 5 | 86.54 | Test | 89.07 | −2.53 | 6 | ||
| 9 | 300 | 10 | 0.010 | 5 | 90.05 | Training | 89.07 | 0.97 | 6 | ||
| Initial Cr(VI) | 10 | 240 | 5 | 0.010 | 5 | 69.61 | Training | 64.91 | 4.70 | 5 | |
| 11 | 240 | 10 | 0.010 | 5 | 59.12 | Training | 64.91 | −5.79 | 5 | ||
| 12 | 240 | 50 | 0.010 | 5 | 62.69 | Training | 64.91 | −2.22 | 5 | ||
| 13 | 240 | 100 | 0.010 | 5 | 49.87 | Training | 33.33 | 16.55 | 8 | ||
| 14 | 240 | 200 | 0.010 | 5 | 25.04 | Test | 33.33 | −8.29 | 8 | ||
| Melanin | 15 | 240 | 10 | 0.005 | 5 | 29.56 | Training | 30.56 | −0.99 | 3 | |
| 16 | 240 | 10 | 0.010 | 5 | 53.22 | Test | 64.91 | −11.69 | 5 | ||
| 17 | 240 | 10 | 0.050 | 5 | 67.97 | Training | 64.91 | 3.06 | 5 | ||
| 18 | 240 | 10 | 0.100 | 5 | 84.65 | Training | 86.75 | −2.10 | 7 | ||
| 19 | 240 | 10 | 0.200 | 5 | 90.65 | Training | 86.75 | 3.90 | 7 | ||
| pH | 20 | 240 | 10 | 0.010 | 2 | 99.84 | Training | 95.36 | 4.48 | 4 | |
| 21 | 240 | 10 | 0.010 | 4 | 94.76 | Training | 95.36 | −0.60 | 4 | ||
| 22 | 240 | 10 | 0.010 | 5 | 76.97 | Training | 64.91 | 12.06 | 5 | ||
| 23 | 240 | 10 | 0.010 | 7 | 64.89 | Training | 64.91 | −0.02 | 5 | ||
| 24 | 240 | 10 | 0.010 | 9 | 39.22 | Test | 41.18 | −1.96 | 9 | ||
| 25 | 240 | 10 | 0.010 | 11 | 23.77 | Training | 24.83 | −1.07 | 10 | ||
| Fungal Biomass | Melanin | ||||
|---|---|---|---|---|---|
| Model Summary | Total predictor | 4 | 4 | ||
| Important predictor | 4 | 4 | |||
| Terminal node | 18 | 10 | |||
| Minimum terminal node size | 1 | 1 | |||
| Statistics | Training | Test | Training | Test | |
| R2, % | 96.26 | 94.60 | 96.70 | 95.90 | |
| Root mean squared error | 5.0599 | 5.7665 | 5.4176 | 6.1535 | |
| Mean squared error | 25.6025 | 33.2528 | 29.3509 | 37.8658 | |
| Mean absolute deviation | 2.4584 | 3.3704 | 3.5080 | 3.9997 | |
| Mean absolute percent error | 0.0557 | 0.0832 | 0.0700 | 0.0855 | |
| Standard deviation | 26.4345 | 25.3274 | 30.1164 | 31.0030 | |
| Number of cases | 50 | 25 | 50 | 25 | |
| DT Model | Investigated Parameters | Cr(VI) Removal, % | Terminal Node | |||||
|---|---|---|---|---|---|---|---|---|
| Contact Time, min | Initial Cr(VI), mg/mL | Fungal Biomass (g) | Melanin (g) | pH | Predicted | Actual | ||
| Fungal biomass | 220 | 70 | 0.100 | - | 3.0 | 99.04 | 98.28 ± 0.24 | 6 |
| 230 | 75 | 0.050 | - | 4.0 | 83.67 | 86.00 ± 0.56 | 7 | |
| 240 | 75 | 0.120 | - | 5.0 | 85.33 | 84.35 ± 0.80 | 15 | |
| Melanin | 240 | 75 | - | 0.100 | 4.5 | 95.36 | 86.04 ± 0.50 | 4 |
| 280 | 70 | - | 0.070 | 5.0 | 89.07 | 91.22 ± 0.29 | 6 | |
| 220 | 70 | - | 0.100 | 5.0 | 86.75 | 80.21 ± 0.28 | 7 | |
Disclaimer/Publisher’s Note: The statements, opinions and data contained in all publications are solely those of the individual author(s) and contributor(s) and not of MDPI and/or the editor(s). MDPI and/or the editor(s) disclaim responsibility for any injury to people or property resulting from any ideas, methods, instructions or products referred to in the content. |
© 2023 by the authors. Licensee MDPI, Basel, Switzerland. This article is an open access article distributed under the terms and conditions of the Creative Commons Attribution (CC BY) license (https://creativecommons.org/licenses/by/4.0/).
Share and Cite
Fakhry, H.; Ghoniem, A.A.; Al-Otibi, F.O.; Helmy, Y.A.; El Hersh, M.S.; Elattar, K.M.; Saber, W.I.A.; Elsayed, A. A Comparative Study of Cr(VI) Sorption by Aureobasidium pullulans AKW Biomass and Its Extracellular Melanin: Complementary Modeling with Equilibrium Isotherms, Kinetic Studies, and Decision Tree Modeling. Polymers 2023, 15, 3754. https://doi.org/10.3390/polym15183754
Fakhry H, Ghoniem AA, Al-Otibi FO, Helmy YA, El Hersh MS, Elattar KM, Saber WIA, Elsayed A. A Comparative Study of Cr(VI) Sorption by Aureobasidium pullulans AKW Biomass and Its Extracellular Melanin: Complementary Modeling with Equilibrium Isotherms, Kinetic Studies, and Decision Tree Modeling. Polymers. 2023; 15(18):3754. https://doi.org/10.3390/polym15183754
Chicago/Turabian StyleFakhry, Hala, Abeer A. Ghoniem, Fatimah O. Al-Otibi, Yosra A. Helmy, Mohammed S. El Hersh, Khaled M. Elattar, WesamEldin I. A. Saber, and Ashraf Elsayed. 2023. "A Comparative Study of Cr(VI) Sorption by Aureobasidium pullulans AKW Biomass and Its Extracellular Melanin: Complementary Modeling with Equilibrium Isotherms, Kinetic Studies, and Decision Tree Modeling" Polymers 15, no. 18: 3754. https://doi.org/10.3390/polym15183754
APA StyleFakhry, H., Ghoniem, A. A., Al-Otibi, F. O., Helmy, Y. A., El Hersh, M. S., Elattar, K. M., Saber, W. I. A., & Elsayed, A. (2023). A Comparative Study of Cr(VI) Sorption by Aureobasidium pullulans AKW Biomass and Its Extracellular Melanin: Complementary Modeling with Equilibrium Isotherms, Kinetic Studies, and Decision Tree Modeling. Polymers, 15(18), 3754. https://doi.org/10.3390/polym15183754

